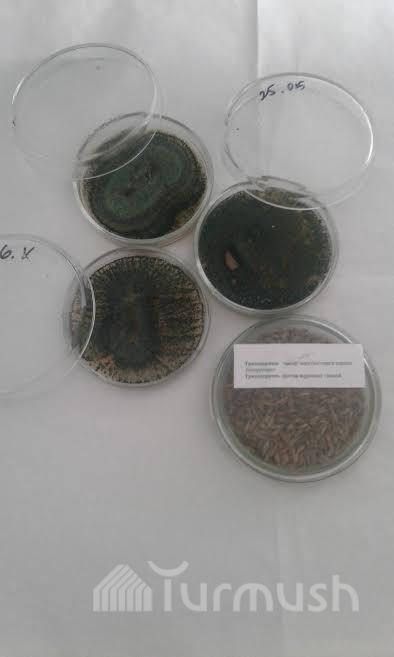

АКИpress'тин кыргыз тилиндеги маалыматтарынын толук архиви (коомдук-саясий жаңылыктар, маданият, кылмыш жана кырсыктар, спорт, ошондой эле аймактардагы маалыматтар)
бир жаңылык950 сомСатып алуу
бир жыл3500 сомкатталуу?
Бул тариф жеке тараптарга гана тиешелүү. Эгерде материалдарга корпоративдик негизде каттала турган болсоңуз (уюмдар, мамлекеттик мекемелер, ведомстволор жана башка) бизге байланышсаңыз болот. Электрондук дарек: info@akipress.org